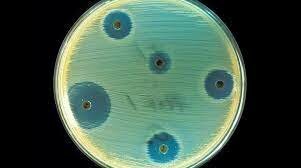
Comercialización de la penicilina.

-
 Por primera vez la biotecnología se usa en Egipto para la producción de cerveza y pan usando la técnica de fermentación.
Por primera vez la biotecnología se usa en Egipto para la producción de cerveza y pan usando la técnica de fermentación. -
 Robert Hooke descubrió las células observando en el microscopio una laminilla de corcho, dándose cuenta de que estaba formada por pequeñas cavidades poliédricas que recordaban a las celdillas de un panal. … Por ello cada cavidad se llamó célula.
Robert Hooke descubrió las células observando en el microscopio una laminilla de corcho, dándose cuenta de que estaba formada por pequeñas cavidades poliédricas que recordaban a las celdillas de un panal. … Por ello cada cavidad se llamó célula. -
 El químico francés Louis Pasteur desarrolla el proceso de pasteurización, con el fin de matar todas las bacterias patógenas y reducir la actividad enzimática.
El químico francés Louis Pasteur desarrolla el proceso de pasteurización, con el fin de matar todas las bacterias patógenas y reducir la actividad enzimática. -
 Gregor Mendel, el padre de la genética descubre las leyes de la herencia
Gregor Mendel, el padre de la genética descubre las leyes de la herencia -
 La palabra biotecnología es usada inicialmente por el ingeniero húngaro Karl Ereky.
La palabra biotecnología es usada inicialmente por el ingeniero húngaro Karl Ereky. -
 Descubrimiento de la penicilina como antibiótico por el bacteriólogo Alexander Fleming.
Descubrimiento de la penicilina como antibiótico por el bacteriólogo Alexander Fleming. -
Debido a su importancia la penicilina comienza a producirse a gran escala.
Debido a su importancia la penicilina comienza a producirse a gran escala. -
 Oswald Avery descubrió junto con su colaborador Maclyn McCarty, que el ADN es el material del que los genes y los cromosomas están formados.
Oswald Avery descubrió junto con su colaborador Maclyn McCarty, que el ADN es el material del que los genes y los cromosomas están formados. -
 Primer organismo transgénico: una bacteria E.coli diseñada a través de la técnica del ADN recombinante.
Primer organismo transgénico: una bacteria E.coli diseñada a través de la técnica del ADN recombinante. -
 Primeras pruebas de campo con tomate y papa resistentes a enfermedades virales. Se producen plantas transgénicas resistentes a herbicidas.
Primeras pruebas de campo con tomate y papa resistentes a enfermedades virales. Se producen plantas transgénicas resistentes a herbicidas. -
 Proyecto internacional de investigación científica con el objetivo fundamental de determinar la secuencia de pares de bases químicas que componen el ADN e identificar y cartografiar todos los genes de un genoma humano
Proyecto internacional de investigación científica con el objetivo fundamental de determinar la secuencia de pares de bases químicas que componen el ADN e identificar y cartografiar todos los genes de un genoma humano -
 El primer animal de establo clonado a partir de una célula de adulto en Escocia
El primer animal de establo clonado a partir de una célula de adulto en Escocia -
 En 2004 a que la FAO apoye el uso de los cultivos obtenidos por técnicas de ingeniería genética como una herramienta complementaria a las técnicas agrícolas tradicionales para ayudar a los campesinos y consumidores en los países en vías de desarrollo.
En 2004 a que la FAO apoye el uso de los cultivos obtenidos por técnicas de ingeniería genética como una herramienta complementaria a las técnicas agrícolas tradicionales para ayudar a los campesinos y consumidores en los países en vías de desarrollo.
Looking for a timeline maker?
Create timelines for projects, roadmaps, history, lessons, legal cases, and stories with Timetoast. Timetoast is a timeline maker for work, school, research, and stories.
